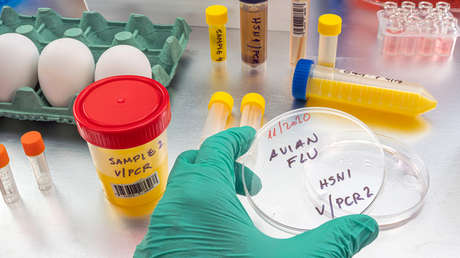
Imagen ilustrativa

Se ha declarado una Zona de Prevención de la Influenza Aviar (AIPZ por sus siglas en inglés) en toda la isla de Gran Bretaña, según el comunicado publicado por el Gobierno británico. La nueva medida se aplicó tras el aumento del número de detecciones de la gripe del pollo.
A partir del lunes, será un requisito legal para todos los criadores de aves en Gran Bretaña seguir estrictas medidas de bioseguridad para ayudar a proteger sus bandadas de la amenaza de la gripe aviar.
Por ejemplo, los criadores con más de 500 aves de corral tendrán que restringir el acceso de personas no esenciales a ellas, y los trabajadores tendrán que cambiarse de ropa y calzado antes de entrar en los recintos. Sin embargo, los propietarios de granjas con un número menor de aves también tendrán que tomar medidas para limitar el riesgo de que la enfermedad se propague entre sus animales.
"La introducción de una AIPZ significa que, independientemente de si se tienen unas pocas aves o miles, se está obligado legalmente a cumplir unos requisitos de bioseguridad reforzados para proteger a las aves de esta enfermedad altamente infecciosa", afirmaron los jefes de los Servicios Veterinarios de Inglaterra, Escocia y Gales en su declaración.
La gripe aviar circula de forma natural en las aves silvestres y puede propagarse fácilmente a las aves cautivas. Sin embargo, las autoridades afirman que el riesgo de propagación del virus para la salud pública es muy bajo y que la gripe aviar supone un riesgo muy bajo para la seguridad alimentaria de los consumidores. Las aves de corral y los productos avícolas, incluidos los huevos, debidamente cocinados son seguros para el consumo.
La zona de prevención de la gripe aviar se mantendrá hasta nuevo aviso.
Europa está experimentando el mayor brote de gripe aviar "altamente patógena" jamás observado en el continente. Unos 48 millones de aves han sido sacrificadas desde el 2021.